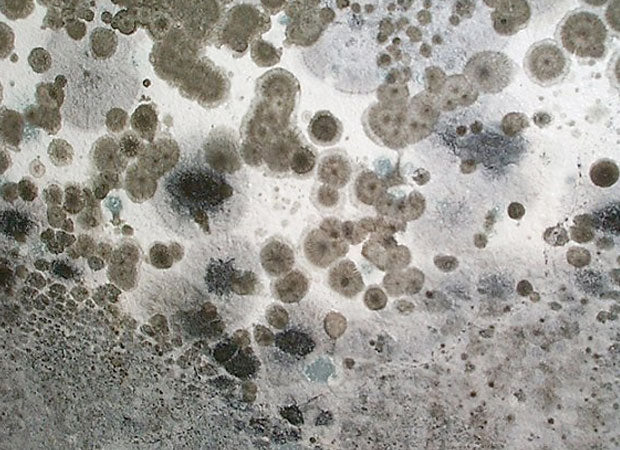

The Asthma and Allergy Foundation of America states that “as many as 30 percent of adults and 40 percent of children” suffer from allergies.
Whether it’s food, dust, pollen or mold, a wide variety of allergens can trigger reactions in individuals, and these allergic reactions can range from the mild to the extreme.

Some sufferers experience respiratory problems, while others experience significant hair loss. In fact, increasingly, many individuals who are allergic to mold experience dramatic hair loss--which is both embarrassing and stressful.
How does mold cause hair loss?
When you come into contact with an allergen such as mold, it triggers the production of a chemical called histamine in your body.

According to The Belgravia Centre, a London-based hair clinic, histamine also causes inflammation which restricts blood flow to the hair follicles.
The lack of adequate blood flow can damage the hair follicles and cause hair to fall out.
In other words, your hair roots are nourished by tiny blood vessels called capillaries. If the circulation to your capillaries is disrupted, then your hair can break easily or fall out.
While short-term exposure to mold can cause temporary hair loss, long-term exposure can lead to consistent hair loss, or even baldness.
How to Treat Hair Loss Caused by Mold
The first thing you should do, if you suspect that you are experiencing an allergic reaction to mold, is find and eliminate the mold source.
You should thoroughly inspect your home for mold, or consider having your home mold tested to be sure.

If you do find mold in your home, then you should begin taking steps to remove it (see Mold Removal). Regularly HEPA vacuuming your home also helps to reduce mold allergies by minimizing mold spores.
Mold Removal Considerations
It is important to have the mold removed from your home as quickly as possible so that your hair will stop falling out and your other symptoms will dissipate.
However, if you experience severe reactions to mold, including ones that cause you to lose hair, then you should not attempt to remove the mold yourself as it will only further aggravate your allergies and may even lead to serious illness.
For instance, other mold-related health problems include respiratory problems, coughing, sneezing, eye infections (like conjunctivitis or pink eye), ear infections, sore throats, sinus infections, bronchitis, asthma attacks and/or hives.

To protect yourself, get a professional company to inspect and clean your home. In fact, many mold removal professionals offer free consultations to discuss the mold issues you might be experiencing in your home.
If you do decide to get your home professionally cleaned, make sure to ask about safety precautions you can take to protect yourself during the mold removal process.
If you decide to have someone else clean your mold for you, and they are not a professional, make sure they take the proper precautions when cleaning. For helpful DIY cleaning steps check HERE.

Treatment for Hair Loss Caused by Mold
After you've dealt with any mold problems in your home, you should talk to a doctor or allergist about your hair loss and allergy symptoms.
If you are unsure of your symptoms, this Mold Symptoms page has a wealth of information on mold allergies, symptoms, causes and treatments.
It is important to understand your symptoms, because you may have other types of physical reactions to mold, in addition to your hair loss.

Additionally, hair loss can be caused by other factors, so your doctor will need to perform a variety of tests, including blood tests.
Then, if your doctor determines that an allergic response to mold is causing you to lose hair, you may be referred to an allergist, a doctor that specializes in the treatment of allergies.
Allergy testing, a procedure in which your skin is pricked with various allergens to see which ones cause a reaction, may be performed to confirm the diagnosis,
Be sure to let your doctor know about all the symptoms you are experiencing, even if they seem unrelated to your loss of hair. Also, let your doctor know if you have been exposed to mold.
Medical Treatments for Mold Allergies
A mold allergy may be treated with antihistamines and corticosteroids to reduce inflammation and other symptoms. Allergy shots, also called immunotherapy, may be recommended in some cases.

Immunotherapy involves receiving weekly injections with a customized serum designed to stimulate your body to develop resistance to allergens, similar to the way vaccines work.
In order to recover fully, however, and stop losing hair, you’ll need to arrange to have the mold removed from your home as well.
After an Allergic Reaction, Can Hair Grow Back?
Hair loss caused by mold exposure can be reversed. Although the regrowth might be slow, in most cases the hair will grow back once a person is no longer exposed to mold.
If you have lost hair from mold exposure you should talk to your doctor about treatments as soon as possible.This will give you the best chance for maximum regrowth.
Time is of the essence when dealing with hair loss due to mold reactions because after long periods distress, hair follicles can die. Once a hair follicle is dead, your hair will not grow back.

However, if you are able to heal the follicle before it dies, then hair can grow again.
Other Hair Loss Remedies
You can check with your doctor if other hair loss remedies might work for you. For instance, some natural remedies have been able to prevent or remedy hair loss, such as Pro Hair 2 formula, a completely safe and natural formula approved by Health Canada.

The formula uses traditional Chinese herbs and roots that have been clinically proven to boost your immune system and accelerate the nutrient absorption by your body and hair.
Those who take it often experience better overall health and stamina in addition to renewed hair growth. However, as with all types of hair loss treatment, it is always best to consult your doctor before beginning anything.

3 comments
This is like a very refreshing OK post for me to research. It’s not every day that I have the possibility to see something like this.. thanks you
https://rajahoki.xn—6frz82g/
https://rtprajahoki.xn—6frz82g/
36 hour cialis online
buy generic cialis online cheap